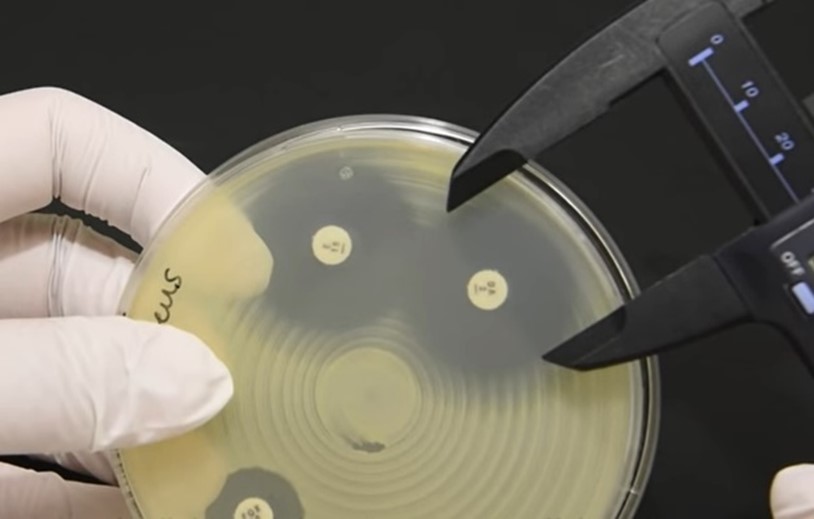

Étape 1 : Lecture des résultats
La lecture de l’antibiogramme est effectuée après incubation de 16 à 24h. La lecture des zones d’inhibition est réalisée à complète inhibition de la culture à l’œil nu, la gélose placée à environ 30 cm de l’œil. La mesure précise du diamètre de la zone d’inhibition en millimètres est réalisée avec un décimètre ou un pied à coulisse, mais un lecteur automatique peut aussi être utilisé.

Dans le cas d’une gélose MH, la lecture se fait sur le dos de la boîte, sur un fond noir
En revanche, pour une gélose MH-F, la lecture se fait face à la boîte de Petri, couvercle enlevé sur un fond clair.

Présence de colonies isolées ?
Il est possible que des colonies isolées puissent être observées au sein de la zone d’inhibition. Ceci peut provenir d’une contamination du milieu de culture, il est donc nécessaire d’en contrôler la pureté, le cas échéant, il faut refaire la suspension bactérienne au complet. Cependant, si les cultures isolées sont apparues malgré la pureté de la suspension, il faut alors prendre en compte leur présence dans la mesure du diamètre de la zone d’inhibition et ne pas les inclure dans la mesure.

Bordures des zones d’inhibition floues ?
Par ailleurs, lorsque les bordures des zones d’inhibition sont floues, le lecteur doit suivre les instructions standard de lecture et estimer les bords de la zone d’inhibition.
Étape 2 : Interprétation
Une fois le diamètre de la zone d’inhibition mesuré, celui-ci est reporté dans des abaques de valeurs de référence éditées par la CA-SFM. (https://www.sfm-microbiologie.org/2021/04/23/casfm-avril-2021-v1-0/) Ces tableaux regroupent les données permettant d’établir, à partir du diamètre de la zone d’inhibition, le statut d’une souche bactérienne vis-à-vis des antibiotiques testés.
Les souches sont catégorisées en :
- Souches dites « Sensibles », sont celles pour lesquelles la probabilité de succès thérapeutique est forte en cas de traitement systémique avec une posologie recommandée par le résumé des caractéristiques du produit (RCP).
- Souches dites « Résistantes » sont celles pour lesquelles un échec du traitement est fort probable.
- Souches dites « Intermédiaires » sont les souches pour lesquelles le résultat in vitro n’est pas prédictible de l’évolution thérapeutique : le succès ou l’échec thérapeutique est imprévisible.
| Diamètre ∅ (mm) | |
| Sensible | ∅ ≥ D |
| Résistant | ∅ < d |
| Intermédiaire | d ≤ ∅ < D |
Exemple d’interprétation d’un antibiogramme :

Principe général des résultats obtenus après réalisation d’un antibiogramme par la méthode des « disques » pour trois antibiotiques testés.
